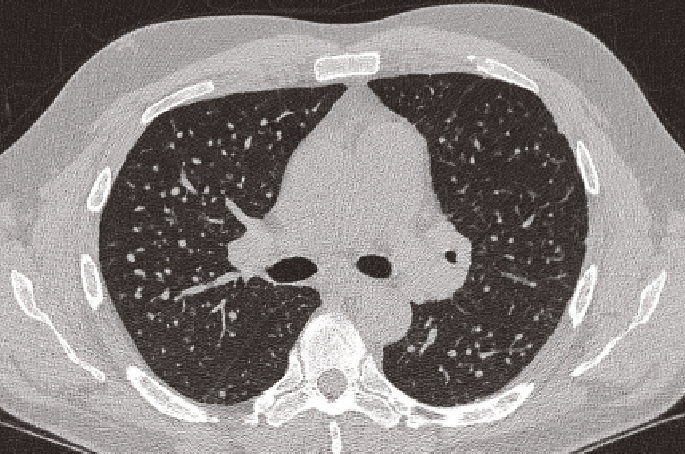

Tecnologías de filtración y sistemas de extracción e inyección para erradicar toxicidad
El control del calor, pero, sobre todo, de los contaminantes pululantes en un ambiente cerrado, resulta una actividad laboriosa, y no cualquier sistema se debe dar a la tarea. Desde la planeación y configuración inicial, hasta la ejecución del proyecto, los sistemas de ventilación y extracción involucrados, deben ser de primera calidad, operados por expertos en el tema.
Trabajadores y civiles que estén constantemente expuestos a la sílice cristalina, resultarán en daños irreversibles a la salud. Algunos de los padecimientos más comunes, pero fatales, son:
- Cáncer de pulmón
- Insuficiencia renal crónica
- Enfermedades autoinmunes
- A veces, se facilitaría la tuberculosis
Los factores clave para contraer silicosis, radica en los tiempos de exposición, así como en los niveles de contaminantes de la sílice en el ambiente. En el peor de los casos, si cupiera esa aseveración, la silicosis es capaz de desarrollarse en menos de una década; esto sucede cuando las exposiciones son muy frecuentes y en altas concentraciones. Normalmente la adquisición de la enfermedad ocurre en un período de veinte a treinta años.
En ese sentido, todo proceso industrial debe poseer en su respectiva área, la mejor ventilación posible, porque los operarios e ingenieros de planta, son los más expuestos a todo tipo de toxinas, incluidos los polvos de sílice cristalina, la causante de afecciones pulmonares, y aunque, los macrófagos son las células que intentarán protegernos de tales intrusiones en los tejidos, cuando no lo logran, simplemente se formarán nódulos fibróticos en los pulmones, dificultando la respiración de manera paulatina y creciente, por el aumento de las cicatrices debido a la constante exposición.
Síntomas de la silicosis en el cuerpo humano
Estas señales claras del cuerpo, dependerán del tiempo de exposición y a las concentraciones de los cristales de sílice. Como se ha mencionado, estos síntomas se pueden presentar hasta mucho después. Pero hay que saber, que mientras avanza la enfermedad, las complicaciones son latentes, detonando enfermedades que no son tan comunes, con otras partes del cuerpo involucradas.
Síntomas básicos:
- Respiración difícil; una sensación de falta de oxígeno.
- Tos seca o con flema.
- Malestar general; dolor en articulaciones o falta de energía.
Síntomas avanzados:
- Dificultad para dormir con alteraciones en sus ciclos.
- Pérdida de apetito con minimización de raciones e incluso sin ganas de probar bocado alguno.
- Dolor torácico punzante.
- La tos con flema se vuelve sangre.
- Insuficiencia cardiaca.
- Uñas de color azul.
La silicosis daña sistemáticamente la salud de trabajadores y civiles en torno a una zona industrial, afecta gravemente su calidad de vida, hasta deteriorarla a niveles irreversibles y fatales. El monitoreo ambiental y biológico, son actividades preponderantes, que deben enforcarse en la atmósfera laboral, pero también en cada una de las personas involucradas, porque las afectaciones podrían variar de una a otra. La ventilación y extracción óptima, debe ser el eje central de una climatización sana.

